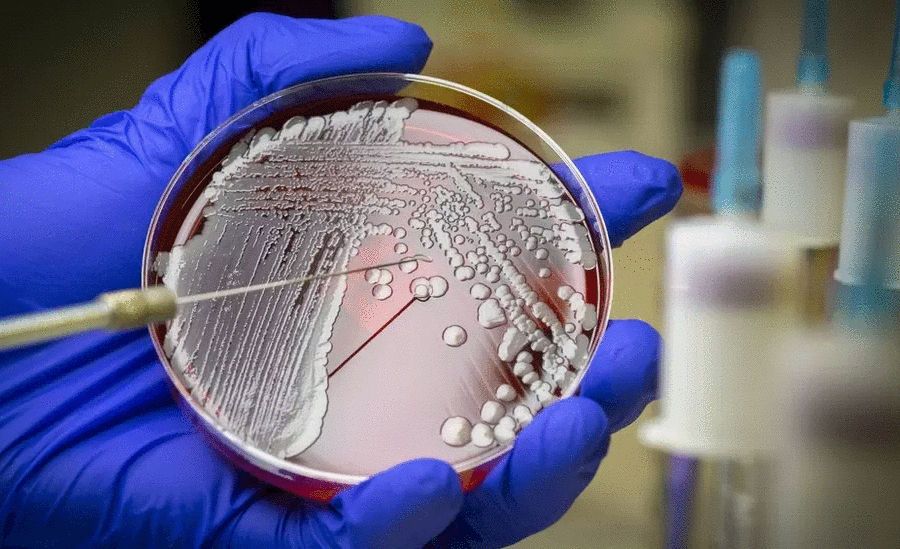
Τα μικρόβια κάνουν πάρτυ και στα νοσοκομεία της Κρήτης

Της Άννας Κωνσταντουλάκη
Με τις ενδονοσοκομειακές λοιμώξεις σχετίζονται χιλιάδες θάνατοι ετησίως στα νοσοκομεία της Ελλάδας, ενώ και στην Κρήτη το πρόβλημα είναι επίσης σοβαρό, καθώς προσβάλλονται 100 στους 1000 νοσηλευόμενους ασθενείς.
Πρόκειται για μια παγκόσμια απειλή, σύμφωνα με τον πρόεδρο της Επιτροπής Ελέγχου και Πρόληψης Λοιμώξεων στα νοσοκομεία της Κρήτης καθηγητή Διαμαντή Κοφτερίδη, ο οποίος έχει τονίσει κατ’ επανάληψη ότι αν δεν ληφθούν μέτρα, οι προβλέψεις είναι δραματικές.
Ποια είναι αυτά τα μέτρα: Είναι η ορθολογική χρήση των αντιβιοτικών, αφού ως γνωστόν η Ελλάδα κάνει πρωταθλητισμό στην Ευρώπη ,στην κατάχρησή τους.
Ακόμη η εφαρμογή όλων των αυστηρών πρωτόκολλων σε σχέση με την τήρηση των κανόνων υγιεινής μέσα στους νοσοκομειακούς χώρους. Οι μονάδες εντατικής θεραπείας όπου χορηγούνται πολλά και ισχυρά αντιβιοτικά, τα χειρουργεία, αλλά και οι κοινοί θάλαμοι ασθενών, βρίθουν ανθεκτικών μικροβίων.
Όπως είπε στην «Π» ο κ. Κοφτερίδης, έρευνα που έγινε στην Κρήτη το 2022 έδειξε ότι από τους 1000 ασθενείς που νοσηλευόταν μια συγκεκριμένη ημέρα σε όλα νοσοκομεία του νησιού, οι 100 είχαν προσβληθεί από κάποια ενδονοσοκομειακή λοίμωξη.
Ο πρωταθλητισμός της Ελλάδας
Πρώτη είναι η Ελλάδα στην ΕΕ όσον αφορά τους θανάτους από πολυανθεκτικά μικρόβια, εξαιτίας της κατάχρησης αντιβιοτικών.
Τη θλιβερή πρωτιά της Ελλάδας στην κατανάλωση αντιβιοτικών και τις σοβαρές επιπτώσεις της στη δημόσια υγεία, υπογράμμισαν οι επιστήμονες που συμμετείχαν στην ενημερωτική ημερίδα, που συνδιοργανώθηκε από τον ΕΔΟΕΑΠ με το Ελληνικό Διαδημοτικό Δίκτυο Υγιών Πόλεων , τον Ιατρικό Σύλλογο Αθηνών και την Ελληνική Εταιρεία Χημειοθεραπείας .
Το 2020 η Ελλάδα ήταν πρώτη, με 2.000 θανάτους, από πολυανθεκτικά μικρόβια στην ΕΕ ενώ ήταν μόνο 100 στη Νορβηγία και 300 στη Σουηδία, ανέφερε η Ελένη Γιαμαρέλλου, καθηγήτρια Παθολογίας- Λοιμώξεων ΕΚΠΑ, συντονίστρια της Ομάδας Μελέτης της Ελληνικής Εταιρείας Χημειοθεραπείας και μέλος της Επιτροπής Εμπειρογνωμόνων του υπουργείου Υγείας.
Παρουσίασε τη στατιστική εικόνα της Ελλάδας μεταξύ των χωρών της Ευρώπης, που την καθιστούν σταθερά πρώτη στην υπερκατανάλωση αντιβιοτικών, με συνέπεια την ανάπτυξη μικροβιακής αντοχής στην κοινότητα, από το 2011 έως σήμερα και υπογράμμισε τις βασικές αρχές που πρέπει να ακολουθούν οι γιατροί για τη συνταγογράφηση, ώστε να σταματήσει η κατάχρηση των αντιβιοτικών.